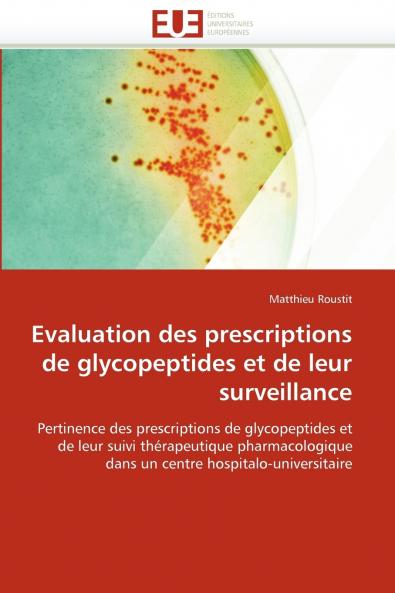
Evaluation des prescriptions de glycopeptides et de leur surveillance

by
TBD
French
Paperback
₹4389
(All inclusive*)
Delivery Options
Please enter pincode to check delivery time.
*COD & Shipping Charges may apply on certain items.
Review final details at checkout.
Looking to place a bulk order? SUBMIT DETAILS
About The Book
Description
Author
Les glycopeptides sont des antibiotiques indiqués dans les infections sévères à cocci à Gram positif. Toutefois leur mésusage conduit à des résistances aux conséquences cliniques et épidémiologiques graves. Nous avons évalué la pertinence et la conformité des prescriptions de glycopeptides (vancomycine et teicoplanine) ainsi que leur surveillance pharmacologique au Centre hospitalier universitaire de Grenoble. Ce travail révèle une pertinence des prescriptions de glycopeptides satisfaisante dans notre établissement. Toutefois les efforts éducatifs doivent porter sur leurs modalités de prescription et de surveillance et notamment sur le suivi thérapeutique pharmacologique.
Delivery Options
Please enter pincode to check delivery time.
*COD & Shipping Charges may apply on certain items.
Review final details at checkout.
Details
ISBN 13
9786131564185
Publication Date
-28-02-2018
Pages
-68
Weight
-106 grams
Dimensions
-152x229x4.25 mm